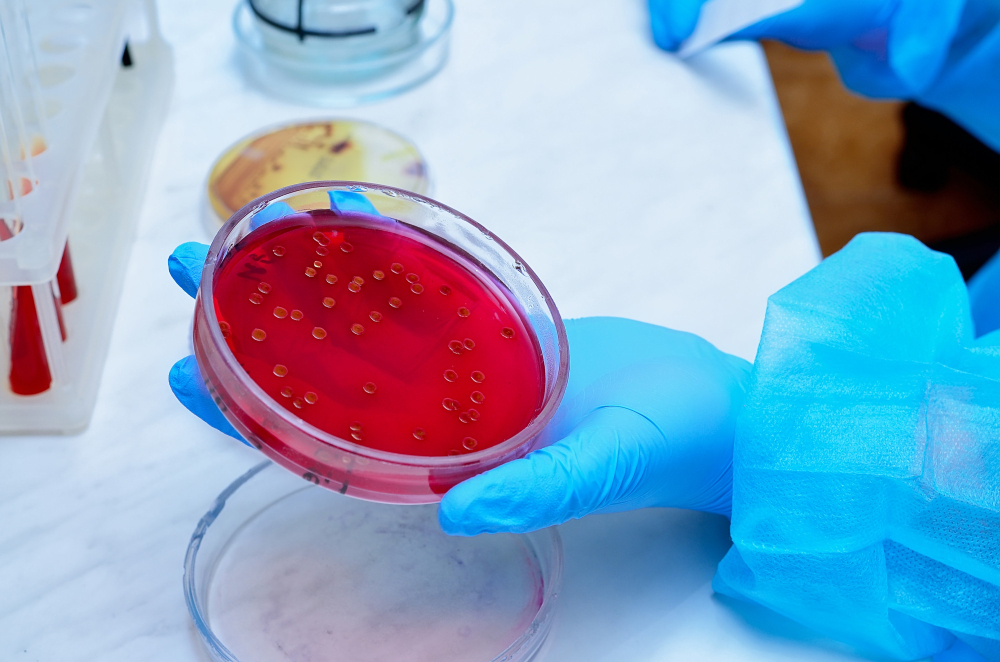

Blood Culture: Detecting Sepsis-Causing Bacteria for Early Diagnosis
What is a Blood Culture? A blood culture is a simple test that checks for bacteria in your blood. Doctors use it to find out
What is a Blood Culture? A blood culture is a simple test that checks for bacteria in your blood. Doctors use it to find out

What Is Inflammation and Why Does It Matter? Inflammation is your body’s natural way to fight off harm. For example, it helps heal cuts and

What Is an Iron Studies Test? An iron studies test is a blood test that checks how much iron is in your body. Doctors use

Introduction: Understanding the Thyroid and Its Role The thyroid is a small gland in your neck. It makes hormones that help control your body’s energy

December is a busy month for many people. However, it is also a great time to focus on your health. The primary keyword, Top 5

Vitamin D deficiency in rural India is becoming a serious health concern. Many people in these areas do not get enough vitamin D, which is

Anaemia in winter is more common than many people think. During cold months, some people notice winter anaemia symptoms like tiredness or weakness. Seasonal anaemia

What is a Liver Function Test? A liver function test is a simple blood test. It checks how well your liver is working. Doctors use

What is a Diabetes Screening Test? A diabetes screening test checks your blood sugar levels. It helps find out if you have diabetes or are

Introduction The Procalcitonin Test is a simple blood test that helps doctors check for serious infections. This test measures the level of procalcitonin, a substance

Introduction A hormone panel test checks the levels of different hormones in your blood. These hormones control many body functions, like growth, mood, and energy.